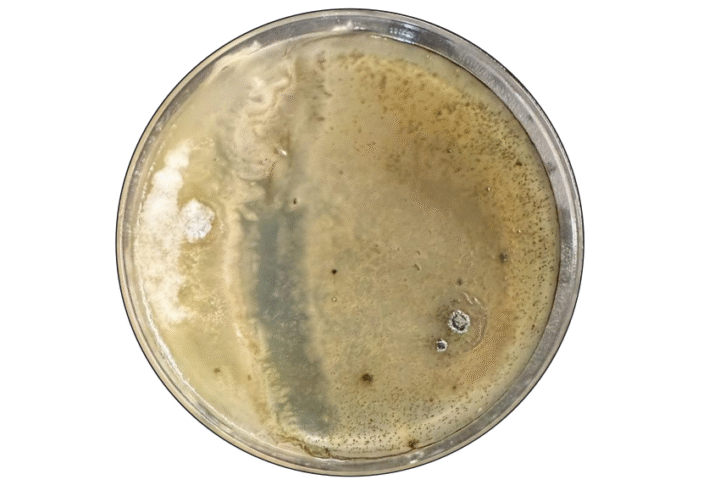
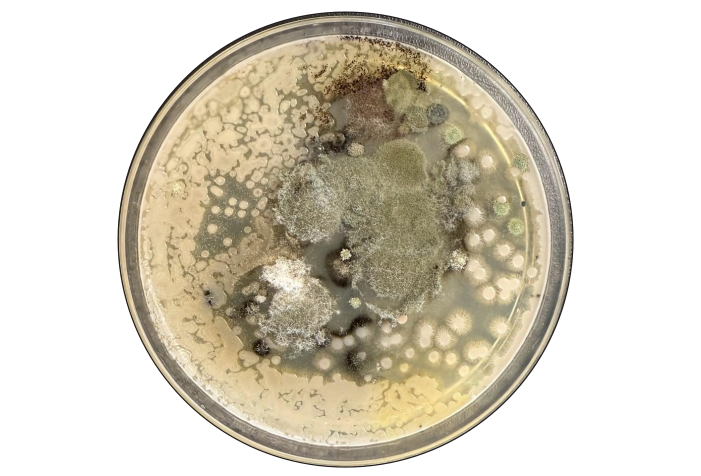

今回は、国立大学の学生寮(国際シェアハウス)で発生したカビ問題の原因を調査しました。
この寮には、留学生を中心とした多国籍の学生たちが生活しています。
「カビのにおいが気になる」「壁にシミのような跡が出てきた」といった相談が相次ぎ、大学から正式に依頼を受けました。
私たちハーツリッチ株式会社では、空気中のカビを分析する浮遊菌検査や、壁や天井の水分量を測定する含水率調査などを実施。
これらの科学的な手法を用いて建物の状態を詳しく調べた結果、カビが発生する要因とその仕組みが明らかになりました。
1. 空気中のカビを「見える化」する浮遊菌検査

カビが発生する建物では、「壁や床だけでなく、空気そのものにも菌が漂っている」ことがあります。
そこで今回は、建物全体の空気環境を把握するために浮遊菌検査を行いました。
1-1. 検査の目的と判定基準
まず、建物内の空気にどの程度カビが含まれているかを調べる検査です。
カビの量は「CFU(コロニー形成単位)」という数値で表され、数値が高いほど空気中にカビが多いことを意味します。
以下の基準に沿って、空気の汚染度を判定しています。
測定項目 | 清潔区域 | 準清潔区域 | 準汚染区域 | 汚染区域 |
浮遊カビ数(CFU/100L) | 5以下 | 20以下 | 21〜99 | 100以上 |
この基準は、文部科学省カビ対策専門家会合報告書を参考にしたもので、100CFU/100Lを超える値はカビ繁殖リスクが高いと判断されます。
1-2. 検査結果の傾向と考察
検査の結果、建物内のカビ量は10〜103CFU/100Lの範囲で確認されました。
特に2階で高い値が見られ、放線菌が多く含まれている可能性がありました。
カビの少ない部屋では、培養プレート上の菌はわずかでしたが、カビの多い部屋では多数のコロニー(菌の集まり)が形成され、空気中に目に見えないカビの胞子が多く存在していることが分かりました。
カビの発生が少なかった部屋の培養プレート 10CFU/100L↓
カビが多く検出された部屋の培養プレート 103CFU/100L↓
同じ建物でも、フロアや部屋の位置によってカビ濃度に差があり、換気の流れや湿気のたまり方など、日常の環境条件がカビの発生に影響していることが確認されました。
1-3. 検出された主な菌の種類
今回の検査では、建物内の空気や壁面からアスペルギルス属(青カビ)・クラドスポリウム属(黒カビ)・放線菌の3種類が確認されました。
- アスペルギルス属(青カビ):壁面や室内表面で最も多く検出され、胞子が空気中に漂いやすい菌です。吸い込むことで鼻炎や喘息などのアレルギー症状を悪化させることがあります。
- クラドスポリウム属(黒カビ):湿気に強く、住宅内でも最もよく見られる種類のひとつです。壁紙の裏や結露しやすい場所で繁殖しやすく、アレルギーの原因にもなります。
- 放線菌:カビに似た細菌で、高湿環境を好みます。吸い込むとアレルギーや咳を引き起こすことがあり、日本では「夏型過敏性肺炎」の原因菌としても知られています。
これらの菌はいずれも湿気を好み、長く吸い込むとアレルギー症状や呼吸器への影響など健康被害を引き起こす恐れがあります。
2. 壁の含水率で分かった“結露のサイン”

カビの発生を防ぐうえで重要なのが、「壁や天井の中に含まれる水分量(=含水率)」です。
見た目が乾いていても、内部に水分が残るとカビは再び発生します。
2-1. 含水率の傾向
多くの部屋は1.2〜1.8%と安定していましたが、一部で2〜3%の高い値が確認されました。
含水率3%を示した箇所↓

この数値の違いは、壁内部で結露が繰り返されているサインです。
特に外壁側や梁の下など温度差が大きい場所では高含水になりやすく、また家具の裏や角など風が通りにくい場所でも湿気がこもる傾向が見られました。
2-2. 含水率とカビの関係
調査の結果、含水率が高い場所ほど黒カビや放線菌が多く確認されました。
内部に湿気が残り、乾きにくい状態がカビの栄養源となっていたと考えられます。
一方で、含水率が低い部屋ではカビの発生はほとんど見られませんでした。
つまり、問題は湿度の高さだけではなく、湿気を逃がしにくい構造にあります。
再発を防ぐためには、壁内部の水分を外へ逃がし、空気の流れを整えることが重要です。
3. カビ発生の主な原因は「外気侵入」「換気バランスの乱れ」「生活習慣」
今回の調査で分かったのは、カビの発生は外気の侵入・換気の不均衡・生活習慣の3つが重なって起きていたということです。
言い換えると、「外から入り込む湿気」と「室内にこもる湿気」がぶつかっている状態でした。
3-1. 外気侵入と結露の繰り返し
外壁や窓まわりの気密性が十分でない部分から湿った外気が入り込み、冷えた壁面で結露が発生していました。
この結露が繰り返されることで、壁紙の裏や梁下などに黒カビが広がりやすい環境が生まれます。

3-2. 換気の乱れと負圧
排気ばかりが強く給気が足りないと、室内が負圧になり、外気の湿気を吸い込みやすくなります。
この状態では、「換気しているのに湿気が抜けない」という現象が起こりやすく、結果的にカビの発生を助長します。
3-3. 生活習慣による湿気の蓄積

家具を壁に密着させたり、洗濯物を室内で干したりすると、空気の流れが滞り湿気がこもります。
こうした日常の習慣も、カビを再発させる一因となっていました。
4. カビを根本から防ぐためのリセットと環境改善
カビを根本から防ぐためには、表面をきれいにするだけでは不十分です。
壁の内部や空気の流れに湿気がたまりやすい構造の場合は、室内を一度リセットし、再発しにくい環境を整えることが大切です。
4-1. 壁内部のカビを除去して「乾かす」
カビは目に見える部分だけでなく、壁紙の裏や下地の内部にも広がることがあります。
再発を防ぐには、壁紙を一度はがして内部をしっかり乾燥・防カビ処理し、その上から防カビ性能のある壁紙を張り替える方法が有効です。
内部までしっかり乾かすことで、見えない部分での再繁殖を防ぐことができます。
4-2. 湿気をためない建物へ改善する

カビを繰り返さないためには、建物そのものの弱点を補う必要があります。
具体的には、次のような対策が効果的です。
エアコン配管や窓のすき間をコーキングで補修し、外からの湿気を防ぐ
冷えやすい部分に断熱材を追加し、温度差による結露を減らす
換気のバランスを整え、室内に湿気がこもらないようにする
クローゼットや梁下など、湿気がたまりやすい場所には除湿機を設置する
これらの対策を行うことで、建物全体が湿気を逃がしやすくなり、カビの再発リスクを大幅に減らすことが期待できます。
5. 専門家の視点:カビを生み出すのは建物と暮らしの環境

今回の調査で分かったのは、「カビは掃除不足だけで発生するものではない」ということです。
建物の構造や地域の気候、そして日々の生活環境が重なって起きる現象でした。
主な原因として、次のような点があげられます。
断熱や気密の不足による結露
高湿な気候と、湿気がこもりやすい建物構造
換気不足や家具の配置による空気の滞留
特にこの地域では、秋になっても湿度が高く、カビが成長しやすい状態が続きます。
そのため、掃除や換気に加えて、断熱性や気密性を高め、家具の配置を見直して空気を循環させることが重要です。
構造と暮らしの両面から環境を整えることで、カビを発生させない住まいを維持できます。
6. まとめ:科学的な調査が「安心できる住環境」をつくる
学生寮のように入居者の入れ替わりが多い建物では、生活リズムや換気の使い方が異なるため、湿気がこもりやすく、カビが再発しやすい環境が生まれやすくなります。
一方で、建物自体の構造や湿気の通り道もカビの発生に影響します。
空気中のカビ量や壁の含水率を数値で把握することで、発生の原因と改善ポイントを明確にできます。
こうした科学的な調査に基づく改善は、カビの再発防止と健康リスクの低減に効果的です。
これからのカビ対策は「発生してから取る」ではなく、「発生させない」へ。
定期的な点検と湿度管理を行うことで、建物の寿命を延ばし、快適な環境を維持できます。
ハーツリッチ株式会社では、学校・病院・公共施設などの環境衛生の「見える化」を進め、多くの人が安心して過ごせる空間づくりに取り組んでいます。

